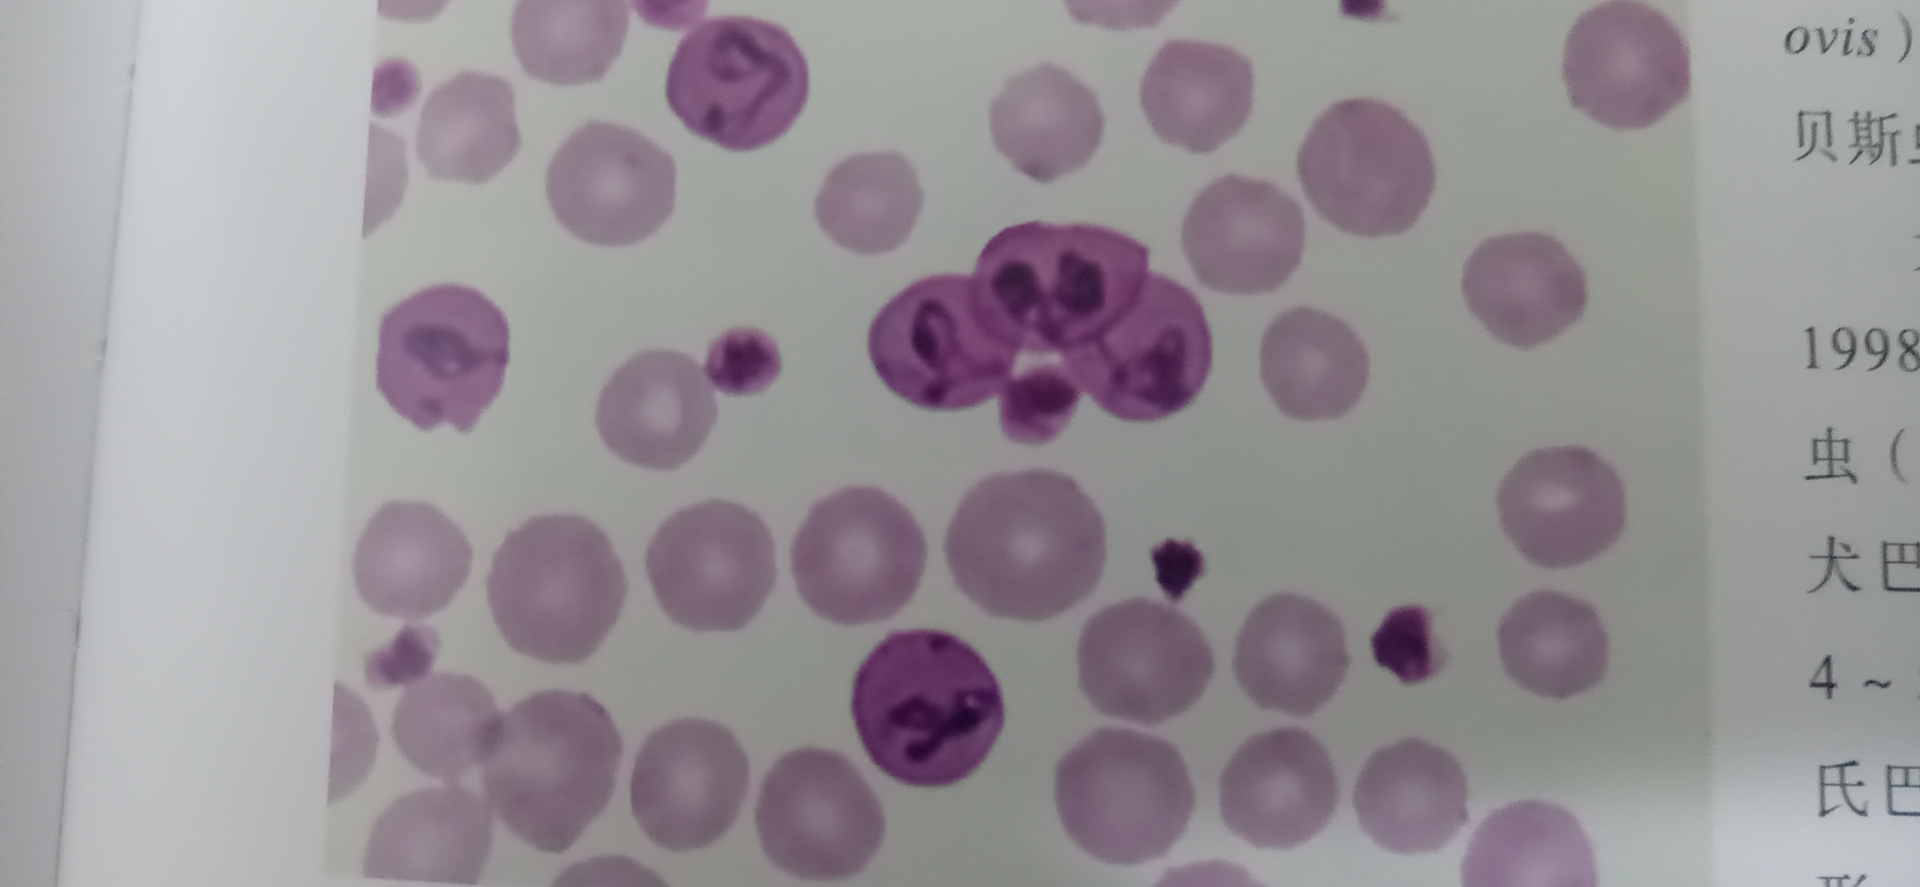

五、典型原蟲病解決方案
1、球蟲弓形體感染:
癥狀:
病初糞便稀薄混有血液,繼而反芻停止,糞中帶血且有惡臭味;隨著病情惡化,出現幾乎全是血液的糞便,體溫下降。尤其是對羔羊危害極大。
?
預防:
①糞便、墊草進行生物發酵處理
②成年牛與犢牛及時隔離飼養
?
治療:
①0.5%地克珠利溶液:每1噸水加本品400ml 混飲,連用5天。
②弓球凈(片劑),內服一次量,每25kg體重牛羊首次量1片,維持量1/5片,一日1次,連用3-5天
上述兩個方案需交替使用,間隔時間6個月。
?
2、抗梨形蟲病感染:
?
牛泰勒蟲:

牛巴貝斯蟲:

?
羊泰勒蟲:

羊巴貝斯蟲:
?
癥狀:
發熱、貧血、黃疸、神經癥狀和血尿,嚴重者可致死。
?
預防:
①控制傳染源
②切斷傳播途徑
③綜合性滅蜱
?
治療:
首選由我國獨創的武四泰寧(50mg/片青蒿琥酯片),內服,一次量,每1kg體重牛、羊5mg,即每10kg體重口服1片。首劑量加倍。一日2次,連用2-4日。孕畜慎用。